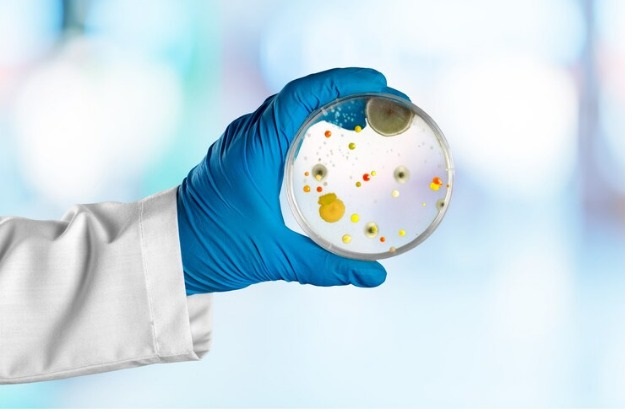

BioTrade Medical supplies LLC
- Biotrade medical supplies LLC is a pioneer company work in field of Medical Laboratory Diagnostic, Point of Care and health care Medical supplies with experience in local and international Market in Germany , China, and Middle east area since 2006
- Biotrade Medical located in Al Khuwair/ Bousher/ Muscat Governorates -Oman, also start business in UAE for import and export for point of care, diagnostic through our office (Biotina LLC) in Sharjah city (shams) P.O Box 515000 Sharjah, UAE. And distribution in UAE through our sister company

BioTrade Medical supplies LLC
Medical & health support for point of Care centers and
chronic disenses paitents need to be use at home
BioTrade Medical supplies LLC
Point of care centers , Diagnostic labs and home health care Market


85+Expert Doctors
150kSatisfy Customers
18+Years of Exprience
Let’s Discuss How We Can Support Your Medical and Health Needs
Meet our awesome Experts
Our ability to deliver outstanding results for our clients starts with our team of experts.


